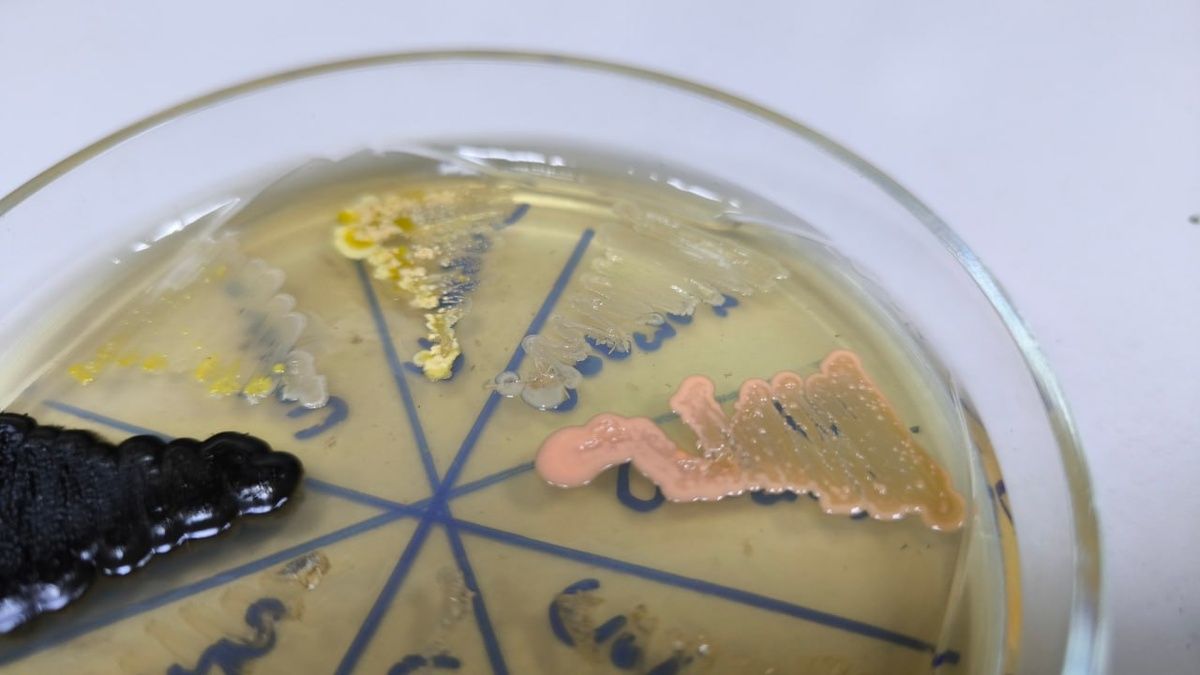
��� ���������������: ������� � ���������

Кулинарные секреты опытных поваров всегда притягивают внимание, и одним из самых интересных является использование соды в приготовлении котлет и других мясных блюд. Этот удивительный ингредиент, который обычно ассоциируется с выпечкой, может произвести чудеса с фаршем, сделав его более сочным и нежным.
Зачем добавлять соду в фарш?
Как показала практика, иногда даже самый качественный фарш может оказаться сухим и жестким, и в этом случае сода становится настоящим спасением. Она не только удерживает влагу в мясной массе, но и выполняет роль разрыхлителя, благодаря чему котлеты остаются мягкими и не разваливаются во время жарки. Эффект будет еще более заметным, если добавить к фаршу немного крахмала.
Рекомендуемая пропорция для достижения наилучшего результата такова: на 0,5 кг мясного фарша следует использовать 0,5 чайной ложки соды. Это правило поможет создать настоящие кулинарные шедевры даже из самого скромного фарша.
Рецепт идеальных котлет с содой
Сода подходит для самых разных мясных блюд, будь то котлеты, тефтели или люля-кебаб. Для приготовления домашних котлет можно воспользоваться следующим проверенным рецептом:
- 500 г свинины
- 60 г белого хлеба
- 45 г лука
- 1 куриное яйцо
- 1 зубчик чеснока
- 0,5 ч. л. соды
- 50 г панировочных сухарей
- 45 г растительного масла для жарки
- Соль и черный перец по вкусу
Приготовьте фарш, используя мясорубку для измельчения лука и чеснока, а также размягченного хлеба. Смешайте ингредиенты, добавьте соду, посолите и приправьте перцем. Вбейте яйцо и тщательно перемешайте массу. Не забудьте об отбивании фарша, оставив его на 15-20 минут для лучшего насыщения кислородом.
Это позволит сделать котлеты еще более воздушными и легкими. Обваляйте их в панировочных сухарях и обжарьте на сковороде с растительным маслом, доведя до золотистой корочки. По завершении жарки накройте котлеты крышкой и потушите в течение 15 минут для достижения максимальной сочности и аромата.
Важно отметить, что сода не нужна для фарша курицы или индейки, так как это мясо само по себе отличается нежностью. Лучше всего использовать этот ингредиент с более грубыми сортами мяса, такими как свинина или говядина.